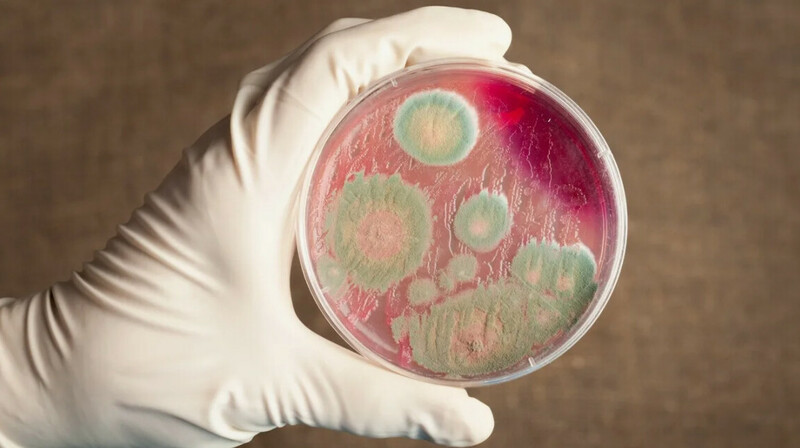
Заболеваемость сибирской язвой в Казахстане снизилась вдвое за 2024 год

4 ноября 2024 г.
/ Новости Казахстана
КазМунайГаз увеличил нефтедобычу на 3%
Казахстанская национальная компания «КазМунайГаз» (КМГ) представила производственные результаты за первые девять месяцев 2024 года, сообщив об увеличении нефтедобычи на 3,1%.